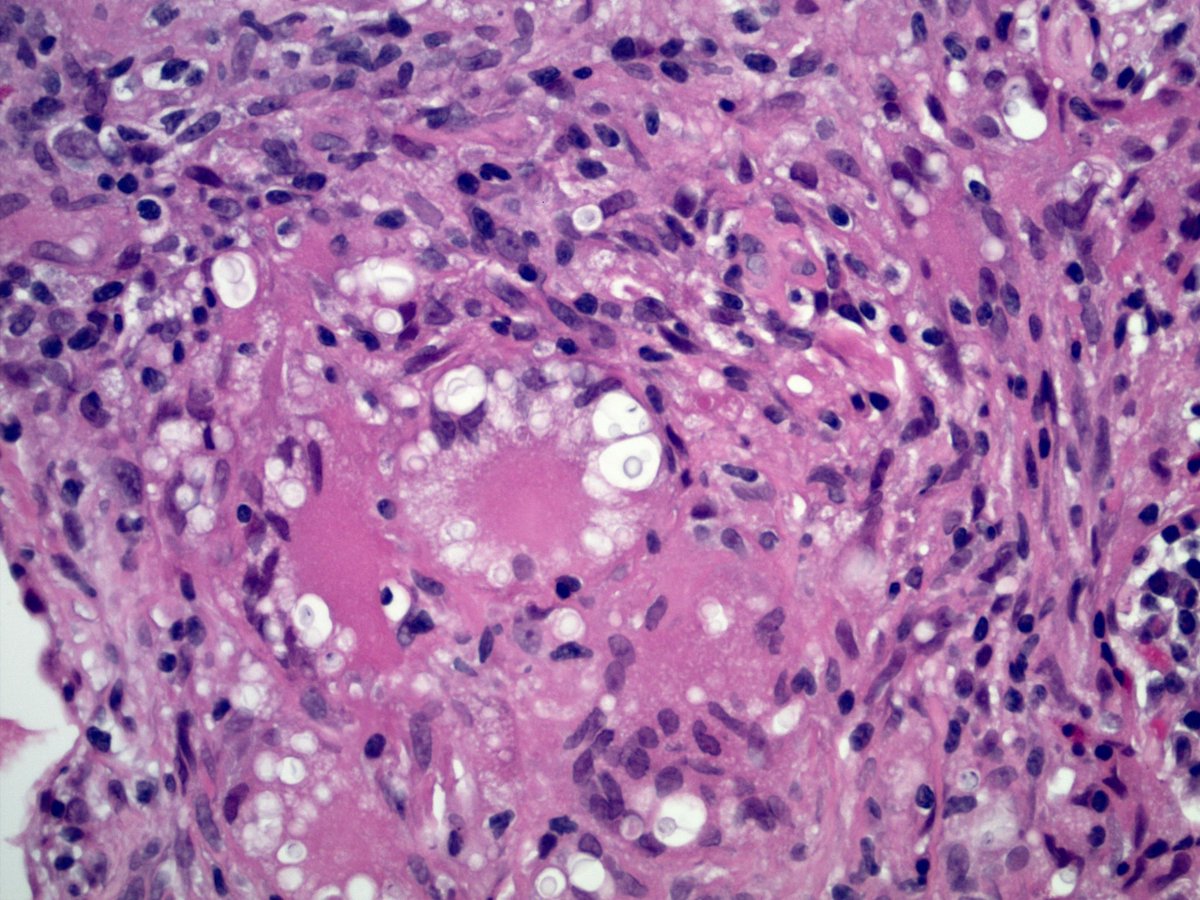

Charles Leduc, MD
@thoracicpath
Thoracic pathologist, University of Montreal Health Center
ID: 1181189361079074816
07-10-2019 12:47:52
319 Tweet
839 Takipçi
246 Takip Edilen





Usual Interstitial Pneumonia shows peripheral, lower predominant fibrosis in the #grosspath by Ángel Romo Microscopically you can appreciate patchy fibrosis, fibroblastic foci & honeycomb #pulmpath #explantsRawesome #transplantpath #ILD



- Lung development stage? Canalicular Lung (16-25 WGA) - Is it perinatal pneumonia? Aspirated amniotic exudate - What are placental findings? Acute Necrotizing Chorioamnionitis with Funisitis #placenta #perinatal (😬 I forgot @basophil_brett) 🥇Leon Metlay 🥈@grenierkarlMD

Barcelona hospital performs first successful transplant on patient with Covid-ravaged lungs in Spain catalannews.com/covid-19/item/… vía Catalan News Vall d'Hebron Cirugía Torácica. Hospital Vall d’Hebron



Do you recognize these seed-derived storage cells (images courtesy of linda johnston)? See the latest publication on these cells and the lesions they produce co-authored by me, Pascual Meseguer. and Pooja Navale MD at rdcu.be/cz4ZC. A Twitter inspired collaboration.



Celina Stayerman MD Carlos Miguel Ruiz Runjan Chetty Laura G. Pastrián MD Monika Vyas Tim Bracey Jamie Sington GI James Vikram Deshpande @CArnold_GI Mark Ong Vidya Monappa The history of Congo red‐stained amyloid is an example of how an erroneous belief can become widely established even when it is contradicted by simple experience: "Congo red‐stained amyloid just shows “apple‐green birefringence" (PMID: 31515863) ncbi.nlm.nih.gov/pmc/articles/P…